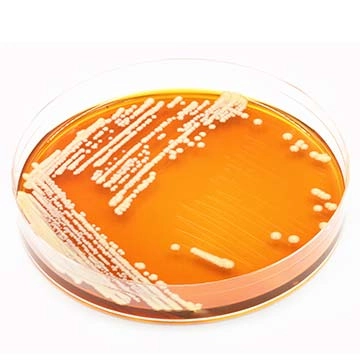
Saccharomyces boulardii

Découvrez tous nos actifs
Le titrage d’un extrait de plante correspond à la concentration précise et garantie du principe actif qui lui confère ses propriétés. Ce titrage standardisé permet une reproductibilité d’une production à une autre. Le Laboratoire LESCUYER s’engage pour vous garantir une qualité constante.
A
C
G
H
Harpagophytum
Hibiscus
Houblon
Huile d'onagre
Huile de bourrache
Huile de foie de morue
Huile de foie de requin
Huile de Nigelle
Huile de noix de coco
Huile de pépins de courge
Huile essentielle d'Eucalyptus globulus
Huile essentielle de lavande aspic
Huile essentielle de thym vulgaire à thymol
Huile essentielle de cannelier de Chine
Huperzia
Hydroxyapatite
Harpagophytum
Hibiscus
Houblon
Huile d'onagre
Huile de bourrache
Huile de foie de morue
Huile de foie de requin
Huile de Nigelle
Huile de noix de coco
Huile de pépins de courge
Huile essentielle d'Eucalyptus globulus
Huile essentielle de lavande aspic
Huile essentielle de thym vulgaire à thymol
Huile essentielle de cannelier de Chine
Huperzia
HydroxyapatiteL
M
P
S
V
Z